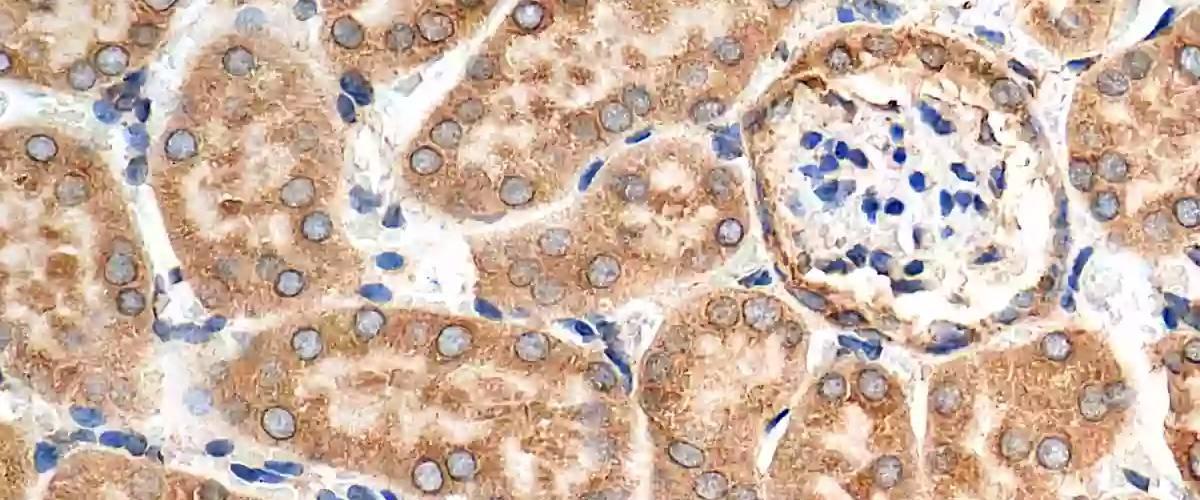
TODO:

Команда из Университета Южной Калифорнии обнаружила: когда клетки находятся в состоянии стресса, белок GPR78 перемещается в ядро и перепрограммирует клетку, запуская процесс миграции — метастазирования опухоли по организму. Обычно GPR78 помогает регулировать свертывание других белков внутри клетки, однако в состоянии стресса происходит сбой.
Открытие стало большой неожиданностью для ученых из-за перемещения GPR78 в ядро клетки. «Это сдвиг парадигмы в клеточной биологии, который будет иметь большое значение для исследований в области терапии рака», — заявила автор исследования Эми Ли. Весьма вероятно, что не только GPR78 обладает такими способностями во время стресса, поэтому открывается широкая область для будущих исследований.
Дальнейшие эксперименты раскрыли механизмы, с помощью которых GPR78 на фоне стресса запускает необходимые сигналы и проникает в ядро, где стимулирует активность гена EGFR и ряда других. Все они в основном связаны с миграцией и инвазией клеток. Примечательно, что ученые также обнаружили связывание GPR78 с другим белком ID2, который обычно подавлял EGFR и другие гены. Тандем GPR78 и ID2 больше не позволял последнему подавлять ассоциированные с метастазированием рака гены.
Теперь ученые получили возможность управлять процессом метастазирования разными способами. Например, снижать активность GPR78 для подавления EGFR или предотвращать его связывание с ID2.
Ранее в другом исследовании ученые представили экспериментальный препарат для блокировки метастазов. Возможно, этот подход станет универсальным для лечения различных типов опухолей на ранней и прогрессирующей стадии.